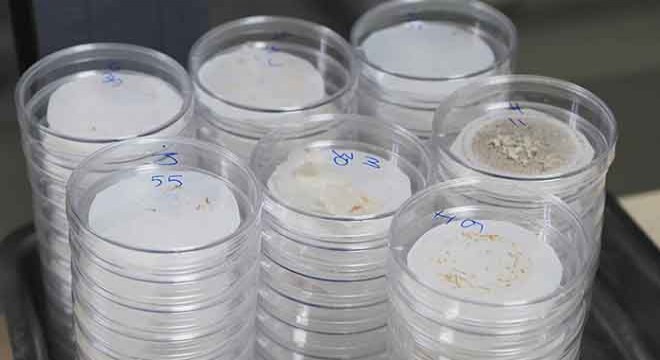
Mikroplastik tehlikesi hayatı tehdit ediyor

Antalya- Alanya D400 kara yolunun Sanayi Kavşağında saat 01.00 sıralarında meydana gelen kazada, Manavgat istikametinden Antalya'ya seyir halindeki 58 NA 312 plakalı tur midibüsü ile Antalya'dan gelip Serik yönüne dönen 07 C 82472 ve 07 C 82257 plakalı otel servis midibüsleri çarpıştı. Kazada isimleri öğrenilemeyen 3 araç sürücüsü ile araçlarda bulunan isimleri öğrenilemeyen 3 kişi yaralandı. İhbar üzerine kaza yerine polis, itfaiye ve çok sayıda sağlık ekibi sevk edildi. Yaralılar olay yerindeki ilk müdahalenin ardından ambulansla ilçedeki hastanelere kaldırıldı. Yaralıların sağlık durumunun iyi olduğu öğrenildi. Polis trafiğe kapanan yolu 1 saat süren çalışmanın ardından açtı. Belediye ekipleri yolda bulunan cam kırıklarını ve yağlanmayı temizledi. Otel servis araçlarının vardiya bitiminde aldığı otel çalışanlarını Serik'e götürdüğü öğrenildi.

Namık Kemal KILINÇ/SERİK, (DHA)

Sayfa başına git
Sayfa başına git